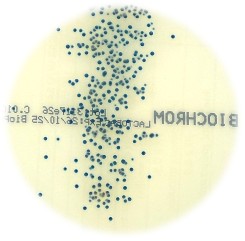
BIOCHROM LACTOBACILLUS AGAR

μικροβιολογικών θρεπτικών υλικών και αντιδραστηρίων.

Η σταθερότητα που χρειάζεστε σε κάθε μέτρηση!


ΤΙ ΚΑΝΟΥΜΕ
In Vitro διαγνωστικά με
υπογραφή Bioprepare
Η εταιρεία Bioprepare που λειτουργεί από το 1993, είναι Ελληνική εταιρεία ειδικευμένη στον τομέα της έρευνας, ανάπτυξης και παρασκευής in vitro διαγνωστικών προϊόντων για κλινικές εφαρμογές.
Τα προϊόντα Bioprepare είναι σύμφωνα με τα πρότυπα της Ε.Ο.Κ. Του Εθνικού Οργανισμού Φαρμάκων (Ε.Ο.Φ.) και φέρουν σήμανση CE.
Η εταιρεία Bioprepare έχει πιστοποιηθεί με ISO 9001: 2015 και ELOT EN ISO 13485: 2016. To 1996 βραβεύτηκε με το 1ο βραβείο καινοτομίας προϊόντων και παραγωγικών διαδικασιών από την Ευρωπαϊκή επιτροπή Γ.Δ.ΧVΙ, το Υπουργείο Ανάπτυξης και τον ΕΟΜΜΕΧ.
Ελληνική τεχνογνωσία με διεθνή πρότυπα
Η Bioprepare λειτουργεί από το 1993, με μακρόχρονη εμπειρία στον σχεδιασμό και την παραγωγή έτοιμων θρεπτικών υλικών και αντιδραστηρίων – για κλινικά, διαγνωστικά και βιομηχανικά εργαστήρια.
Αξιοπιστία & πιστοποιήσεις
Όλα τα προϊόντα έχουν σχεδιαστεί και παρασκευαστεί με πρότυπα ποιότητας. Η έδρα μας βρίσκετε στην Κερατέα Αττικής, με πλήρη υποδομή παραγωγής και διανομής.
Βρείτε πιστοποιητικά ελέγχου
Συμπληρώστε τον κωδικό και τον αριθμό παρτίδας για να εντοπίσετε το σωστό πιστοποιητικό
ΠΛΗΡΟΦΟΡΙΕΣ ΠΡΟΪΟΝΤΩΝ
Όλα όσα χρειάζεστε για την σωστή χρήση των προϊόντων σας
Βρείτε εύκολα και γρήγορα δελτία δεδομένων ασφαλείας, τεχνικές προδιαγραφές και χρήσιμα φυλλάδια για βιομηχανική ή κλινική χρήση
Δελτία Δεδομένων Ασφαλείας
Βρείτε όλα τα δελτία δεδομένων ασφαλείας με όλες τις απαραίτητες πληροφορίες για την ασφαλή χρήση και διαχείριση των προϊόντων.
Τεχνικές Προδιαγραφές
Βρείτε τις πλήρεις τεχνικές προδιαγραφές για κάθε προϊόν, για να εξασφαλίσετε ακρίβεια και αξιοπιστία στην εφαρμογή σας.
Χρήσιμα Φυλλάδια PDF (Βιομηχανία)
Κατεβάστε τα ενημερωτικά φυλλάδια για βιομηχανικές εφαρμογές, με πρακτικές οδηγίες και χρήσιμες πληροφορίες.
Χρήσιμα Φυλλάδια PDF (Κλινική Μικροβιολογία)
Βρείτε όλα τα εξειδικευμένα φυλλάδια για εφαρμογές κλινικής μικροβιολογίας, με έμφαση στην αξιοπιστία και την επιστημονική ακρίβεια.